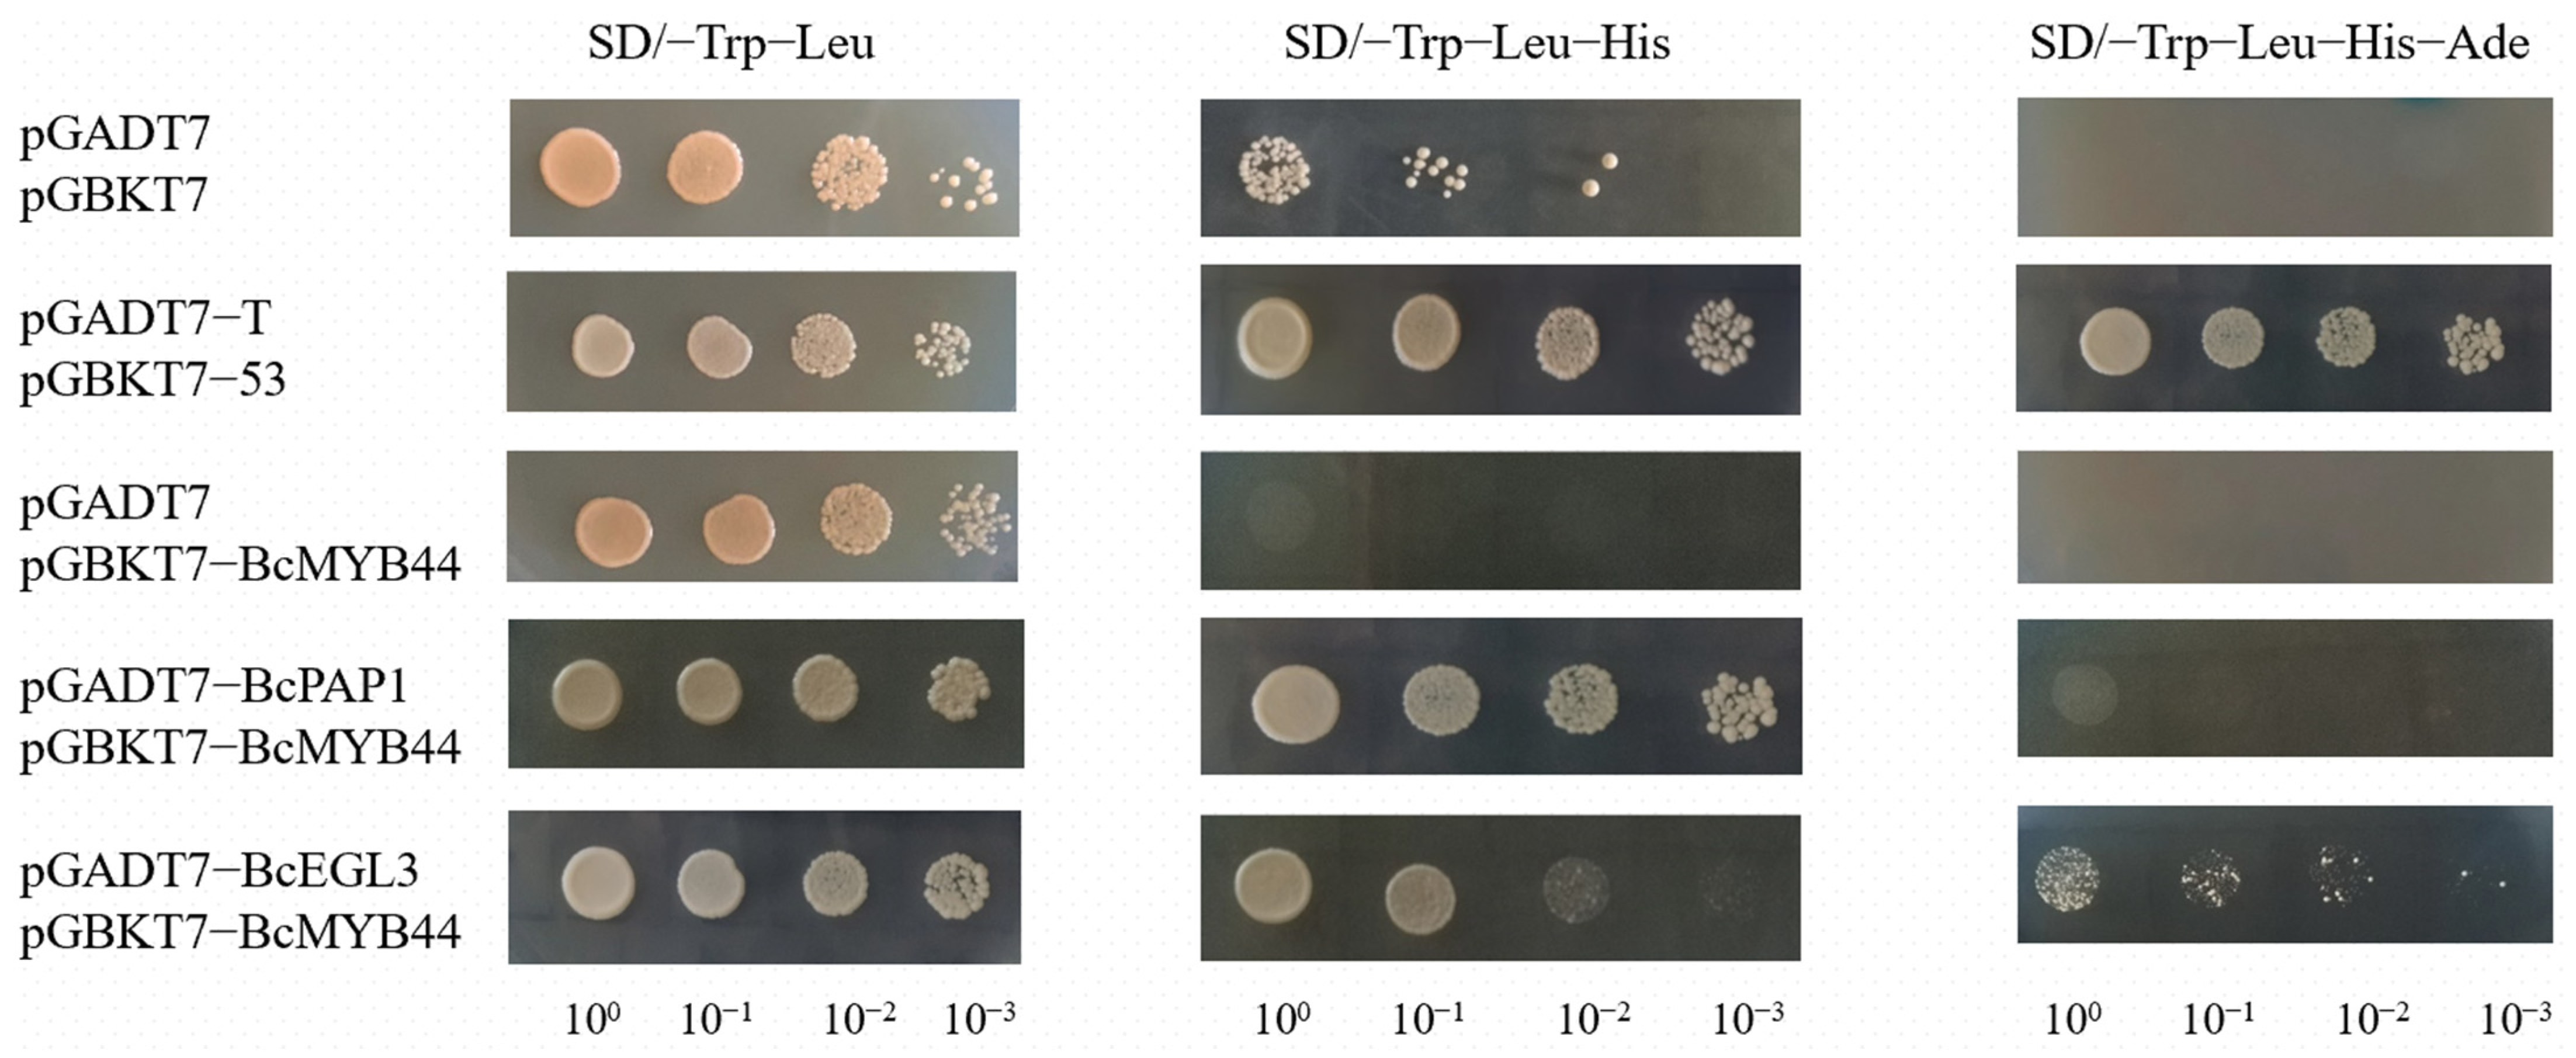
Horticulturae 08 00351 g003

Regulation of BcMYB44 on Anthocyanin Synthesis and Drought Tolerance in Non-Heading Chinese Cabbage (Brassica campestris ssp. chinensis Makino)
Abstract
:1. Introduction
2. Material and Methods
2.1. Plant and Processing Conditions
2.2. Gene Cloning and Sequence Analysis
2.3. Subcellular Localization of BcMYB44
2.4. Y2H Analysis
2.5. BiFC Verification
2.6. Pigment Detection of BcPAP1 and BcMYB44 Protein Activity
2.7. Real-Time Quantitative PCR (RT-qPCR) Analysis
2.8. VIGS Processing
2.9. Determination of Physiological Indicators
3. Results
3.1. Sequence Analysis of BcMYB44
3.2. Subcellular Localization of BcMYB44
3.3. Interaction between BcMYB44 and BcPAP1 and BcEGL3 In Vitro and Vivo
3.4. Pigment Detection of BcPAP1 and BcMYB44 Protein Activity in Anthocyanin Pathway
3.5. VIGS Analysis of BcMYB44
3.6. Analysis of Drought Tolerance of Non-Heading Chinese Cabbage Based on VIGS Treatment
4. Discussion
5. Conclusions
Supplementary Materials
Author Contributions
Funding
Institutional Review Board Statement
Informed Consent Statement
Data Availability Statement
Acknowledgments
Conflicts of Interest
References
- Li, Y.; Liu, G.F.; Ma, L.M.; Liu, T.K.; Zhang, C.W.; Xiao, D.; Zheng, H.K.; Chen, F.; Hou, X.L. A chromosome-level reference genome of non-heading Chinese cabbage [Brassica campestris (syn. Brassica rapa) ssp. chinensis]. Hortic. Res. 2020, 7, 212. [Google Scholar] [CrossRef] [PubMed]
- Hou, X.L.; Li, Y.; Huang, F.Y. The main characters of non-heading Chinese cabbage (Brassica campestris ssp. chinensis) and the new progress of molecular biology research on breeding techniques. Acta Hortic. Sin. 2020, 47, 1663–1677. [Google Scholar]
- Sun, B.; Zhang, F.; Xue, S.L.; Chang, J.Q.; Zhang, A.H.; Jiang, M.; Miao, H.Y.; Wang, Q.M.; Tang, H.R. Molecular Cloning and Expression Analysis of the ζ-Carotene Desaturase Gene in Chinese kale (Brassica oleracea var. alboglabra Bailey). Hortic. Plant J. 2018, 4, 94–102. [Google Scholar] [CrossRef]
- Li, W.X.; Yang, S.B.; He, Z.C.; Jin, B. Research progress in plant leaf color change mechanism. Acta Hortic. Sin. 2017, 44, 1811–1824. [Google Scholar]
- Yang, L.P.; Ling, W.H.; Du, Z.C.; Chen, Y.M.; Li, D.; Deng, S.Z.; Liu, Z.M.; Yang, L.L. Effects of Anthocyanins on Cardiometabolic Health: A Systematic Review and Meta-Analysis of Randomized Controlled Trials. Adv. Nutr. 2017, 8, 684–693. [Google Scholar] [CrossRef]
- Cao, Y.P.; Li, K.; Li, Y.L.; Zhao, X.P.; Wang, L.H. MYB Transcription Factors as Regulators of Secondary Metabolism in Plants. Biology 2020, 9, 61. [Google Scholar] [CrossRef] [Green Version]
- Liu, J.Y.; Osbourn, A.; Ma, P. MYB Transcription Factors as Regulators of Phenylpropanoid Metabolism in Plants. Mol. Plant 2015, 8, 689–708. [Google Scholar] [CrossRef] [Green Version]
- Wang, Y.; Yang, X.; Yang, R.J.; Wang, Y.X.; Yang, F.X. Research progress of MYB transcription factors regulating phenylpropane biosynthesis. J. Anhui Agric. Univ. 2019, 46, 859–864. [Google Scholar]
- Xu, F.; Ning, Y.J.; Zhang, W.W.; Liao, Y.L.; Li, L.L.; Cheng, H.; Cheng, S.Y. An R2R3-MYB transcription factor as a negative regulator of the flavonoid biosynthesis pathway in Ginkgo biloba. Funct. Integr. Genom. 2014, 14, 177–189. [Google Scholar] [CrossRef]
- Yang, W.J. Cloning and Expression of Soybean MYB Transcription Factor Gene; Sichuan Agricultural University: Ya’an, China, 2007. [Google Scholar]
- Wei, Z.Z.; Hu, K.D.; Zhao, D.L.; Tang, J.; Huang, Z.Q.; Jin, P.; Li, Y.H.; Han, Z.; Hu, L.Y.; Yao, G.F.; et al. MYB44 competitively inhibits the formation of the MYB340-bHLH2-NAC56 complex to regulate anthocyanin biosynthesis in purple-fleshed sweet potato. BMC Plant Biol. 2020, 20, 258. [Google Scholar] [CrossRef]
- Wan, D.P. Gene Cloning and Analysis of MYB Transcription Factors of Type V Purple-Spotted White Clover and Tartary BuckWheat; Inner Mongolia Agricultural University: Inner Mongolia, China, 2018. [Google Scholar]
- Seo, P.J.; Xiang, F.; Qiao, M.; Park, J.Y.; Lee, Y.N.; Kim, S.G.; Lee, Y.H.; Park, W.J.; Park, C.M. The MYB96 transcription factor mediates abscisic acid signaling during drought stress response in Arabidopsis. Plant Physiol. 2009, 151, 275–289. [Google Scholar] [CrossRef] [Green Version]
- Feng, C.P.; Andreasson, E.; Maslak, A.; Mock, H.P.; Mattsson, O.; Mundy, J. Arabidopsis MYB68 in development and responses to environmental cues. Plant Sci. 2004, 167, 1099–1107. [Google Scholar] [CrossRef]
- Almeida, T.; Pinto, G.; Correia, B.; Santos, C.; Goncalves, S. QsMYB1 expression is modulated in response to heat and drought stresses and during plant recovery in Quercus suber. Plant Physiol. Biochem. 2013, 73, 274–281. [Google Scholar] [CrossRef]
- Li, Z.Y.; Jiao, Z.X.; Chen, Y.; Gao, F.; Zhou, Y.J. Cloning and expression pattern analysis of Astragalus AmMYB44 gene. Genom. Appl. Biol. 2019, 38, 3605–3613. [Google Scholar]
- Li, J.B.; Zhao, S.; Yu, X.; Du, W.; Li, H.; Sun, Y.; Sun, H.; Ruan, C.J. Role of Xanthoceras sorbifolium MYB44 in tolerance to combined drought and heat stress via modulation of stomatal closure and ROS homeostasis. Plant Physiol. Biochem. 2021, 162, 410–420. [Google Scholar] [CrossRef] [PubMed]
- Chen, Y.P.; Liu, G.N.; Yan, Y.X.; Cao, Z. Effects of drought stress on black rice anthocyanin content and PAL activity. J. Jilin Agric. Sci. Technol. Inst. 2012, 21, 8–10. [Google Scholar]
- Li, Y.F.; Li, Y.H.; Wang, Z.H.; Guan, N.; Feng, C.J.; Yang, J.M. Effects of soil drought stress on the leaf color of purple-leaf dwarf cherry. Acta Ecol. Sin. 2009, 29, 3678–3684. [Google Scholar]
- Xiao, Z. Research on the Functional Differences between Flavonols and Anthocyanins in Plant Stress Resistance; Shandong University: Jinan, China, 2018. [Google Scholar]
- Liu, D.; Zhou, Q.; Kong, X.Y.; Hu, C.M.; Hou, X.L. Cloning and silencing analysis of non-heading Chinese cabbage anthocyanin synthesis transcription factor gene BcEGL3. J. Nanjing Agric. Univ. 2021, 44, 249–258. [Google Scholar]
- Zhu, S.H.; Li, Y.J.; Zhang, X.Y.; Liu, F.; Xue, F.; Zhang, Y.S.; Kong, Z.S.; Zhu, Q.H.; Sun, J. GhAlaRP, a cotton alanine rich protein gene, involves in fiber elongation process. Crop J. 2021, 9, 313–324. [Google Scholar] [CrossRef]
- Janik, K.; Stelmach, H.; Mittelberger, C.; Hause, B. Characterization of Phytoplasmal Effector Protein Interaction with Proteinaceous Plant Host Targets Using Bimolecular Fluorescence Complementation (BiFC). Methods Mol. Biol. 2019, 1875, 177–194. [Google Scholar]
- Hellens, R.P.; Allan, A.C.; Friel, E.N.; Bolitho, K.; Grafton, K.; Templeton, M.D.; Karunairetnam, S.; Gleave, A.P.; Laing, W.A. Transient expression vectors for functional genomics, quantification of promoter activity and RNA silencing in plants. Plant Methods 2005, 1, 13. [Google Scholar] [CrossRef] [Green Version]
- Livak, K.J.; Schmittgen, T.D. Analysis of relative gene expression data using real-time quantitative PCR and the2(-Delta Delta C(T)) method. Methods 2001, 25, 402–408. [Google Scholar] [CrossRef] [PubMed]
- Dong, H.J.; Hou, X.L.; Han, K.; Zhang, Z.S.; Hu, C.M. Cloning and expression analysis of a negative regulatory gene BrcLBD39 for anthocyanin Synthesis and its Response to Exogenous 6-BA in Chinese cabbage. J. Nanjing Agric. Univ. 2018, 41, 49–56. [Google Scholar]
- Huang, C.; Wen, X.; Tang, Y.; Guo, L.Z.; Jiang, S.J.; Dai, Q.L. Effects of exogenous salicylic acid on the physiology of pakchoi seedlings under salt stress. Jiangsu Agric. Sci. 2020, 48, 147–151. [Google Scholar]
- Butt, H.I.; Yang, Z.E.; Gong, Q.; Chen, E.Y.; Wang, X.Q.; Zhao, G.; Ge, X.Y.; Zhang, X.Y.; Li, F.G. GaMYB85, an R2R3 MYB gene, in transgenic Arabidopsis plays an important role in drought tolerance. BMC Plant Biol. 2017, 17, 142. [Google Scholar] [CrossRef]
- Huo, D.; Liu, X.K.; Zhang, Y.; Duan, J.J.; Zhang, Y.L.; Luo, J.R. A Novel R2R3-MYB Transcription Factor PqMYB4 Inhibited Anthocyanin Biosynthesis in Paeonia qiui. Int. J. Mol. Sci. 2020, 21, 5878. [Google Scholar] [CrossRef]
- Matsui, K.; Umemura, Y.; Ohme-Takagi, M. AtMYBL2, a protein with a single MYB domain, acts as a negative regulator of anthocyanin biosynthesis in Arabidopsis. Plant J. Cell Mol. Biol. 2008, 55, 954–967. [Google Scholar] [CrossRef] [PubMed]
- Zhou, H.; Lin, W.K.; Wang, F.; Espley, R.V.; Ren, F.; Zhao, J.; Ogutu, C.; He, H.; Jiang, Q.; Allan, A.C. Activator-type R2R3-MYB genes induce a repressor-type R2R3-MYB gene to balance anthocyanin and proanthocyanidin accumulation. New Phytol. 2019, 221, 1919–1934. [Google Scholar] [CrossRef] [PubMed] [Green Version]
- Faraji, S.; Heidari, P.; Amouei, H.; Filiz, E.; Abdullah; Poczai, P. Investigation and Computational Analysis of the Sulfotransferase (SOT) Gene Family in Potato (Solanum tuberosum): Insights into Sulfur Adjustment for Proper Development and Stimuli Responses. Plants 2021, 10, 2597. [Google Scholar] [CrossRef]
- Liu, Y.H.; Lin, W.K.; Espley Richard, V.; Wang, L.; Li, Y.M.; Liu, Z.; Zhou, P.; Zeng, L.H.; Zhang, X.J.; Zhang, J.L.; et al. StMYB44 negatively regulates anthocyanin biosynthesis at high temperatures in tuber flesh of potato. J. Exp. Bot. 2019, 70, 3809–3824. [Google Scholar] [CrossRef] [Green Version]
- Xu, W.J.; Dubos, C.; Lepiniec, L. Transcriptional control of flavonoid biosynthesis by MYB-bHLH-WDR complexes. Trends Plant Sci. 2015, 20, 176–185. [Google Scholar] [CrossRef] [PubMed]
- Shamloo-Dashtpagerdi, R.; Razi, H.; Ebrahimie, E.; Niazi, A. Molecular characterization of Brassica napus stress related transcription factors, BnMYB44 and BnVIP1, selected based on comparative analysis of Arabidopsis thaliana and Eutrema salsugineum transcriptomes. Mol. Biol. Rep. 2018, 45, 1111–1124. [Google Scholar] [CrossRef] [PubMed]
- Wu, R.G.; Wang, Y.; Wu, T.; Xu, X.F.; Han, Z.H. Functional characterisation of MdMYB44 as a negative regulator in the response to cold and salt stress in apple calli. J. Hortic. Sci. Biotechnol. 2018, 93, 347–355. [Google Scholar] [CrossRef]
- Persak, H.; Pitzschke, A. Dominant repression by Arabidopsis transcription factor MYB44 causes oxidative damage and hypersensitivity to abiotic stress. Int. J. Mol. Sci. 2014, 15, 2517–2537. [Google Scholar] [CrossRef] [PubMed] [Green Version]
- Heidari, P.; Faraji, F.; Ahmadizadeh, M.; Ahmar, S.; Mora-Poblete, F. New Insights into Structure and Function of TIFY Genes in Zea mays and Solanum lycopersicum: A Genome-Wide Comprehensive Analysis. Front. Genet. 2021, 12, 534. [Google Scholar] [CrossRef] [PubMed]

Publisher’s Note: MDPI stays neutral with regard to jurisdictional claims in published maps and institutional affiliations. |
© 2022 by the authors. Licensee MDPI, Basel, Switzerland. This article is an open access article distributed under the terms and conditions of the Creative Commons Attribution (CC BY) license (https://creativecommons.org/licenses/by/4.0/).
Share and Cite
Hao, Y.; Wang, J.; Hu, C.; Zhou, Q.; Mubeen, H.M.; Hou, X. Regulation of BcMYB44 on Anthocyanin Synthesis and Drought Tolerance in Non-Heading Chinese Cabbage (Brassica campestris ssp. chinensis Makino). Horticulturae 2022, 8, 351. https://doi.org/10.3390/horticulturae8050351
Hao Y, Wang J, Hu C, Zhou Q, Mubeen HM, Hou X. Regulation of BcMYB44 on Anthocyanin Synthesis and Drought Tolerance in Non-Heading Chinese Cabbage (Brassica campestris ssp. chinensis Makino). Horticulturae. 2022; 8(5):351. https://doi.org/10.3390/horticulturae8050351
Chicago/Turabian StyleHao, Yuli, Jianjun Wang, Chunmei Hu, Qian Zhou, Hafiz Muhammad Mubeen, and Xilin Hou. 2022. "Regulation of BcMYB44 on Anthocyanin Synthesis and Drought Tolerance in Non-Heading Chinese Cabbage (Brassica campestris ssp. chinensis Makino)" Horticulturae 8, no. 5: 351. https://doi.org/10.3390/horticulturae8050351
APA StyleHao, Y., Wang, J., Hu, C., Zhou, Q., Mubeen, H. M., & Hou, X. (2022). Regulation of BcMYB44 on Anthocyanin Synthesis and Drought Tolerance in Non-Heading Chinese Cabbage (Brassica campestris ssp. chinensis Makino). Horticulturae, 8(5), 351. https://doi.org/10.3390/horticulturae8050351
